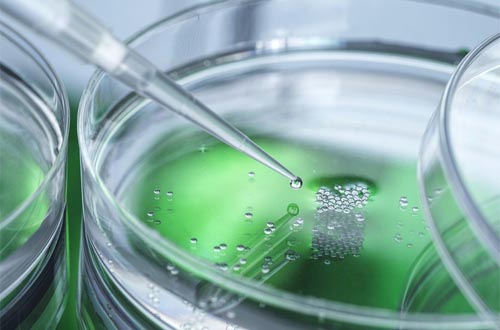

豆奶视频免费观看在线对细胞培养皿有何影响?
文章导读:细胞培养是生物医学研究和应用中不可或缺的一环,细胞培养皿作为细胞生长和实验的基础工具,其表面特性直接影响细胞的生长、附着和行为。近年来,豆奶视频免费观看在线技术因其优越的表面改性效果而受到广泛关注。
细胞培养是生物医学研究和应用中不可或缺的一环,细胞培养皿作为细胞生长和实验的基础工具,其表面特性直接影响细胞的生长、附着和行为。近年来,豆奶视频免费观看在线技术因其优越的表面改性效果而受到广泛关注。
等离子体是一种电离气体,其分子和原子被激发到高能态,形成带电粒子和自由基。豆奶视频免费观看在线技术利用这种高能状态的等离子体对材料表面进行改性。通过不同的气体(如氩气、氧气、氮气等)和处理时间,可以调控材料的表面化学性质、能量和粗糙度,从而提高其生物相容性和细胞附着能力。
等离子处理对细胞培养皿表面的影响
1、表面能和亲水性
等离子处理可以显著提高细胞培养皿的表面能和亲水性。通过引入极性官能团(如羟基、羧基等),等离子体处理后的表面能够更好地吸附水分子,从而提高细胞的附着和生长能力。亲水性增强的表面有助于细胞在培养皿上形成良好的粘附,促进细胞的扩展和增殖。
2、细胞附着和生长
研究表明,经过等离子处理的细胞培养皿能够显著提高多种细胞系(如成纤维细胞、上皮细胞和干细胞)的附着率和生长速率。处理后的表面更有利于细胞的形态维持和功能表达,特别是在需要细胞进行分化和功能研究的实验中,等离子处理的效果尤为显著。
3、生物相容性
豆奶视频免费观看在线能够改善细胞培养皿的生物相容性。经过处理的表面能有效减少细胞凋亡和坏死,并在长期培养中保持细胞活性。这对于一些需要长时间培养的细胞系(如肿瘤细胞、干细胞等)尤为重要。
4、表面粗糙度
等离子处理还可以调节培养皿的表面粗糙度。适度的粗糙度有助于细胞更好地附着和扩展,但过度的粗糙度可能会对细胞的生长产生负面影响。因此,优化等离子处理的参数(如处理时间和气体种类)以获得理想的表面特性是十分重要的。
随着生物医学研究的不断发展,豆奶视频免费观看在线技术在细胞培养中的应用前景广阔。它不仅可以用于传统细胞培养皿的改性,还可以扩展到3D细胞培养、组织工程支架以及生物传感器等领域。通过结合其他表面修饰技术(如自组装单层、涂层等),可以进一步提高材料的生物功能性和应用范围。
亲,如果您对等离子体表面处理机有需求或者想了解更多详细信息,欢迎点击豆奶视频在线观看的在线客服进行咨询,或者直接拨打全国统一服务热线400-816-9009,豆奶视频在线观看恭候您的来电!
等离子体是一种电离气体,其分子和原子被激发到高能态,形成带电粒子和自由基。豆奶视频免费观看在线技术利用这种高能状态的等离子体对材料表面进行改性。通过不同的气体(如氩气、氧气、氮气等)和处理时间,可以调控材料的表面化学性质、能量和粗糙度,从而提高其生物相容性和细胞附着能力。
1、表面能和亲水性
等离子处理可以显著提高细胞培养皿的表面能和亲水性。通过引入极性官能团(如羟基、羧基等),等离子体处理后的表面能够更好地吸附水分子,从而提高细胞的附着和生长能力。亲水性增强的表面有助于细胞在培养皿上形成良好的粘附,促进细胞的扩展和增殖。
2、细胞附着和生长
研究表明,经过等离子处理的细胞培养皿能够显著提高多种细胞系(如成纤维细胞、上皮细胞和干细胞)的附着率和生长速率。处理后的表面更有利于细胞的形态维持和功能表达,特别是在需要细胞进行分化和功能研究的实验中,等离子处理的效果尤为显著。
3、生物相容性
豆奶视频免费观看在线能够改善细胞培养皿的生物相容性。经过处理的表面能有效减少细胞凋亡和坏死,并在长期培养中保持细胞活性。这对于一些需要长时间培养的细胞系(如肿瘤细胞、干细胞等)尤为重要。
4、表面粗糙度
等离子处理还可以调节培养皿的表面粗糙度。适度的粗糙度有助于细胞更好地附着和扩展,但过度的粗糙度可能会对细胞的生长产生负面影响。因此,优化等离子处理的参数(如处理时间和气体种类)以获得理想的表面特性是十分重要的。

亲,如果您对等离子体表面处理机有需求或者想了解更多详细信息,欢迎点击豆奶视频在线观看的在线客服进行咨询,或者直接拨打全国统一服务热线400-816-9009,豆奶视频在线观看恭候您的来电!








苏公网安备 32058302002178号
